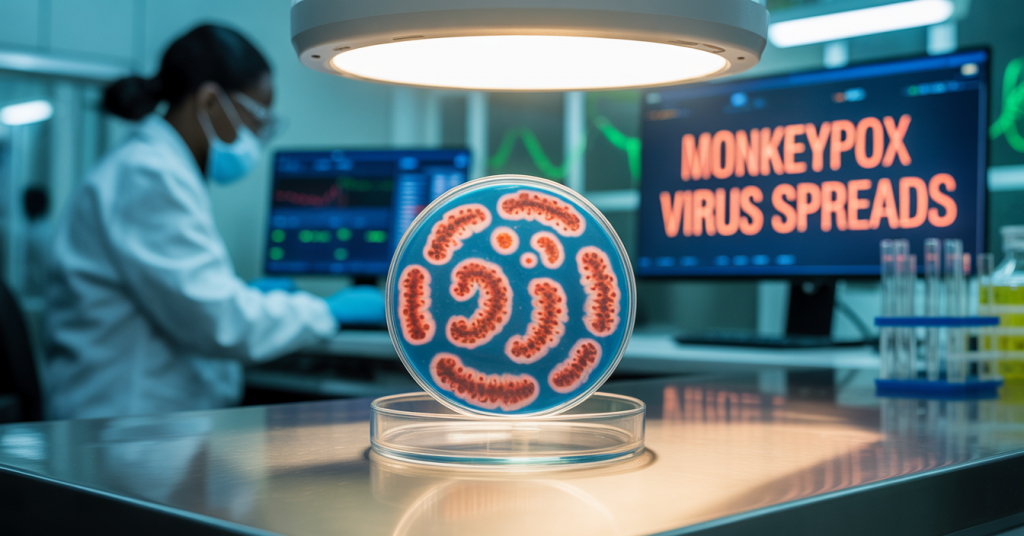
Gana’da Maymun Çiçeği Virüsü Yayılıyor

Konya
Parçalı Bulutlu
30°C
Konya
30°C
Parçalı Bulutlu
Perşembe
Hafif Yağmurlu
31°C
Cuma
Parçalı Bulutlu
30°C
Cumartesi
Parçalı Bulutlu
31°C
Pazar
Parçalı Bulutlu
32°C